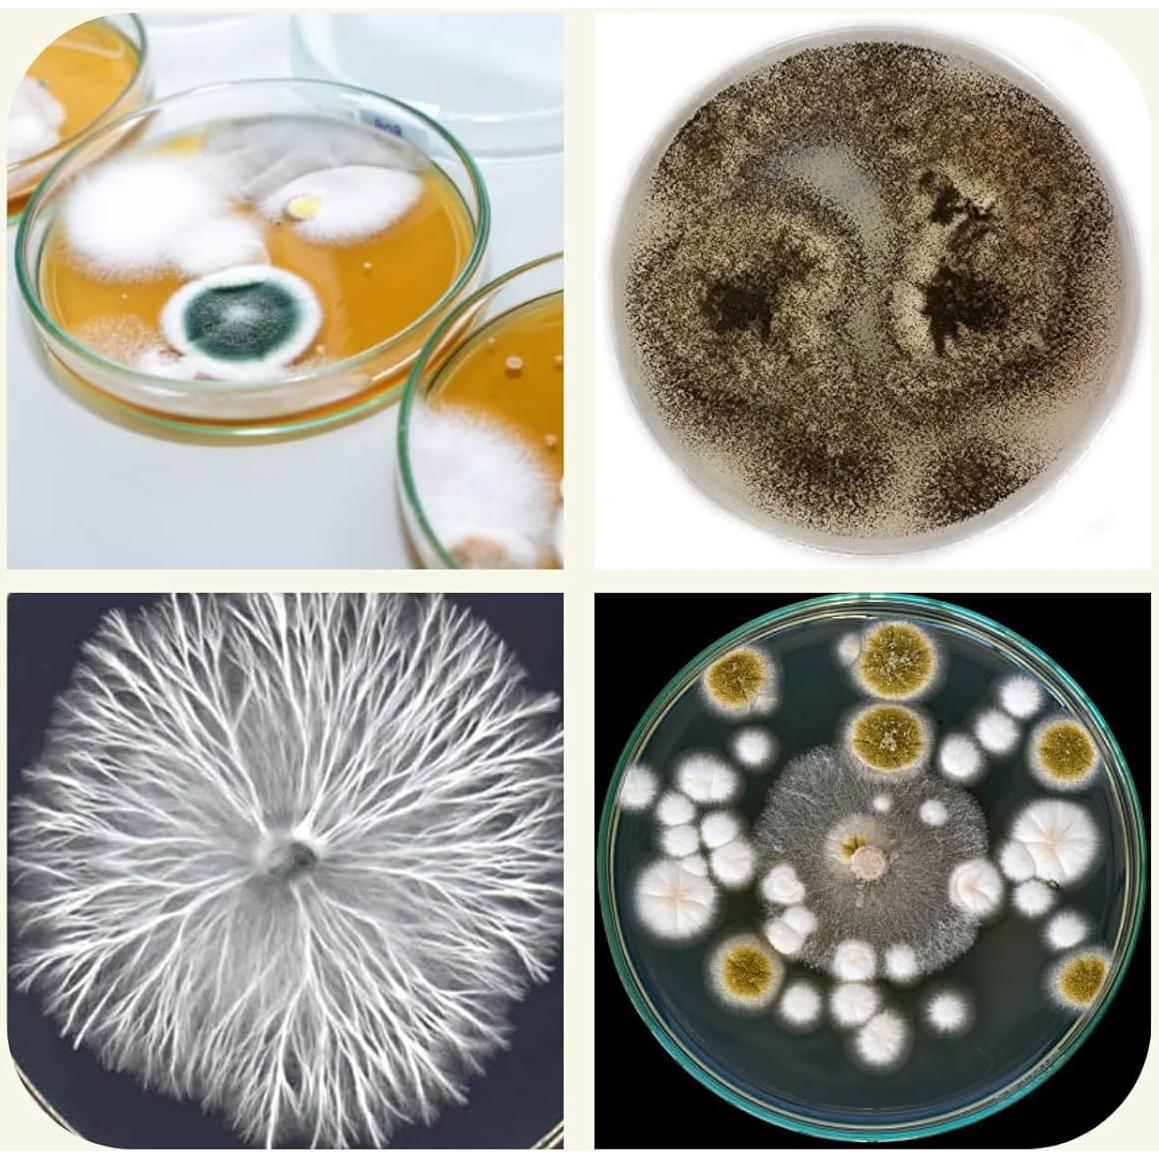
Placas de Agar de Dextrosa de Papa EZ BioResearch - 10 Unidades

Cavisoo
Placas de Agar de Dextrosa de Papa EZ BioResearch - 10 Unidades

100+ vendidos
Placas de Agar de Dextrosa de Papa EZ BioResearch - 10 Unidades
$47.271
+ impuestos: $9.927
Llega a domicilio entre el 5 y el 10 de feb
- Compra protegida
- Envío a todo el país
- Garantía de entrega
Características destacadas
- Las placas de PDA prevertidas están listas para usar, muy convenientes para cultivar hongos.
Opiniones de compradores
769 opiniones
Merissa
cualquier otra empresa de la que pidas va a llegar rota, derramada, mojada, con placas contaminadas. todo el mundo dice que nunca deberías comprar placas de agar en Amazon porque es algo que se explica por sí mismo: necesitas placas limpias, estériles, duraderas y no comprometidas. pero esta empresa las envía perfectas cada vez. la calidad del radar es increíble, la estabilidad del gel no se descompone, no gotea, nunca he tenido un problema y pido todo el tiempo de ellos después de haber tenido
Virgomike
Funciona genial, sin problemas ni inconvenientes. Sin contaminantes, limpio y claro. Fácil de ver, fácil de hacer.
CyberFlyer
Lo bueno: La presentación y el envío fueron geniales. Los platos estaban claros, limpios y venían en una bolsa ziplock. Los proveedores responden rápidamente a las consultas, pero responderán a tu pregunta con más preguntas y no ofrecen soluciones, así que si te gusta ese tipo de cosas, estás en una verdadera delicia. Lo malo: Desgraciadamente, es un desperdicio de dinero. Nada creció en el medio de ninguno de los platos, ni siquiera un indicio de bacterias. Los platos han estado expuestos a tod
Bryan W.
Ninguna de estas placas se contaminó y llevan a un micelio saludable y viable.
Rez
Segunda vez que compro. La primera vez todo fue perfecto. El segundo pedido parecía ser el mismo. Esperé unos días y parece que dos platos terminaron así. ¡Volveré a comprar!
Descripción
Especificaciones técnicas
- Fabricante
- EZ BioResearch LLC
- Dimensiones del paquete
- 21.65 x 13.68 x 13.53 centímetros; 448.24 gramos
- Está descontinuado por el fabricante
- No
Preguntas y respuestas
Tu pregunta fue enviada. Te responderemos pronto.
¿Dónde te enviamos la respuesta?
Tus preguntas
· Recibirás la respuesta a
Productos relacionados
- Garden Republic -






